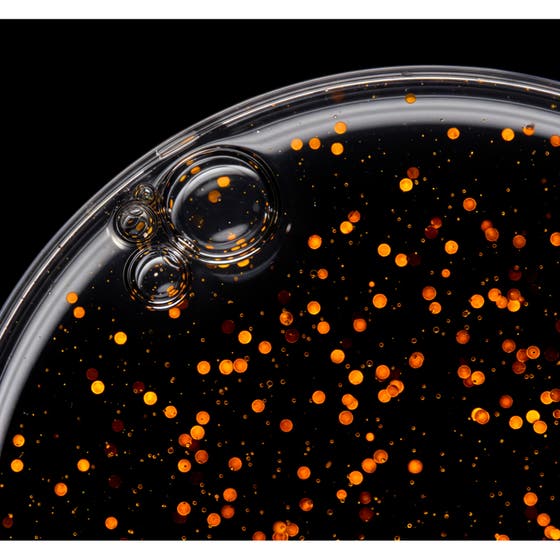
Potion 9 Super Luxe Styling Drops

Sebastian Professional Potion 9 Super Luxe Styling Drops 30 ml
Ej i lager
Utan rabatt 509 kr
381,75 kr
Aktivera din rabatt
Handla valfria varor för 599 kr och få 25% rabatt på massor av hårvård! Gäller t.o.m. 16/4
Fri frakt över 599 kr
Artikel: 196848
Sebastian Professional Potion 9 Super Luxe Styling Drops – upptäck dropparna som gör allt. Denna lätta, hybridbehandling och stylingprodukt i ett ger 9 kraftfulla fördelar i varje droppe. Berikad med mikroinkapslade pärlor och förstärkt med 9 växtbaserade ingredienser ger denna oljebehandling fukt, 72 timmars frisskontroll, värme- och UV-skydd, minskad risk för kluvna toppar och håravbrott, glans, kontroll och definierad styling.
Anpassa mängden efter hårlängd och applicera 5–10 droppar i fuktigt eller torrt hår från mitten av längderna till topparna. Arbeta igenom håret och styla som önskat.
Potion 9 – en behandling som passar alla hårtyper.
Anpassa mängden efter hårlängd och applicera 5–10 droppar i fuktigt eller torrt hår från mitten av längderna till topparna. Arbeta igenom håret och styla som önskat.
Potion 9 – en behandling som passar alla hårtyper.